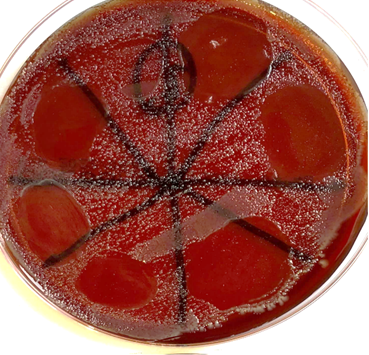
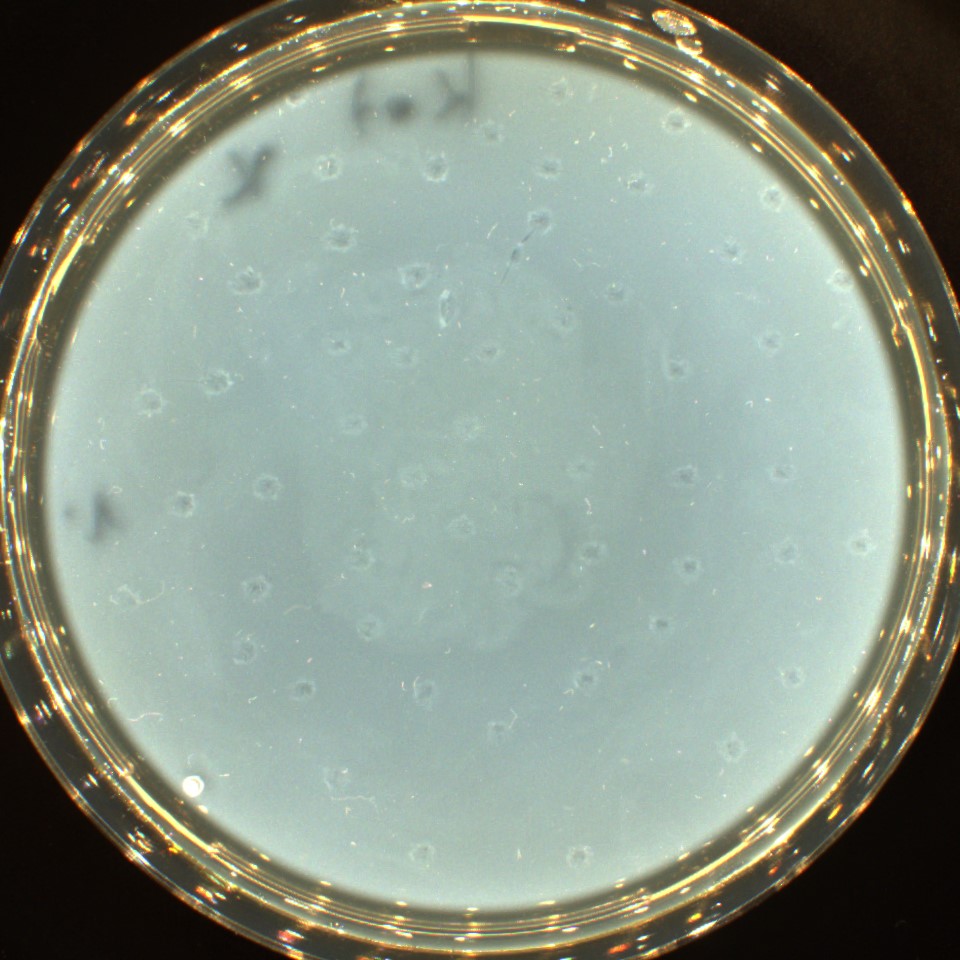

was sind Bakteriophagen?
Wie funktionieren Bakteriophagen?
Bakteriophagen sind Viren, die Bakterienzellen zur Vermehrung benötigen. Sie heften sich an die Bakterienoberfläche und geben über ihre DNA eine kodierte Information an die Bakterienzelle, um neue Bakteriophagen zu produzieren und freizusetzen.
Bei diesem Prozess wird die Bakterienzelle vernichtet, was man im rechten Bild erkennen kann. Bakteriophagen sind sehr wirtspezifisch, das heißt Bakteriophagen, die z.B. Clostridium perfringens zum Vermehren benötigen, können keine andere Bakterienart zerstören. Auf dem fotografierten Agar ist ein Clostridium perfringens-Rasen gewachsen und auf acht Felder wurden Cl. perf.- Monophagen aufgetropft. Auf sechs Feldern ist zu erkennen, dass die aufgetropften Phagen die Clostridien lysiert haben. Zwei weitere Felder sind nach der Inkubationszeit immer noch mit einem geschlossenen Bakterienrasen verblieben, wonach zu urteilen ist, dass diese Monophagen nicht für den Erregerstamm geeignet sind und auch nicht für den Phagencocktail vorgesehen werden.
Eine weitere Eigenschaft ist, dass Bakteriophagen außerhalb ihres Wirtsbakteriums nur wenige Tage überlebensfähig sind. Das heißt, sie sind selbst limitierend.
Mit dem Wissen über diese Eigenschaften lassen sich Bakteriophagen hervorragend für die Kontrolle und Bekämpfung von bestimmten bakteriellen Infektionskrankheiten nutzen.
Historischer Rückblick
1915 hat Frederick Twort auf seiner Agarplatte feststellen können, dass es eine Substanz gibt, die eine kulturelle Anzucht verhindert.
1917 isolierte Felix d´ Hérelle dieses Phänomen und heilte damit Ruhrbazillus-Infektionen beim Menschen. 1919 war es ihm möglich zu identifizieren, dass es sich um Viren handelt, die die Bakterien infizieren und zerstören. In dem Fall arbeitete er mit Hühnerkot, um den Hühnerthyphus zu bekämpfen.

reine Bakteriophagenplaques

Phagenplaques aus einer Wasserprobe
Phagenplaques aus einer Kotprobe
FAQs
Häufig gestellte Fragen zu
dem unbekannten Helfer der Natur.
Diese und weitere Fragen und Antworten sind auf der Website vom Bundesamt für Risiko (www.bfr/bund.de) zu finden.
Gibt es noch offene Fragen?
Kontaktieren Sie uns einfach per Email.
Wir werden Ihre Fragen so schnell wie möglich beantworten.
Kontakt
Phagen kommen überall dort vor, wo ihre Wirtsbakterien leben, also weltweit. Da es etwa zehnmal so viele Phagen wie Bakterien gibt, treten Phagen häufig in sehr großer Zahl auf. So findet man im Wasser von Seen bis zu 100 Millionen Phagen pro Milliliter. In Böden können es sogar bis zu 1 Milliarde Phagen pro Gramm sein. (www.bfr/bund.de)
In der neuen ab dem 1.1.2022 gültigen EU-Arzneimittelverordnung 2019/6 sind unter Artikel 4 (43) in Annex II Abschnitt 8.2.3 (Application for novel therapies) die Vorrausetzungen für ihre Anwendung in der Lebensmittelherstellung definiert. Danach müssen Bakteriophagen vor ihrer Anwendung auf mögliche Virulenz- und Resistenzgene untersucht worden sein. In der Schweiz und einigen europäischen Ländern werden Bakteriophagen bereits in der Oberflächenbehandlung von Lebensmitteln und der Verarbeitung von Milchprodukten erfolgreich eingesetzt.
Ja, lysogene Phagen können in seltenen Fällen Virulenz- oder Resistenzgene in ihrem Erbgut tragen und diese indirekt über Bakterien auf das Tier übertragen. Solche Phagen besitzen die Fähigkeit, nach dem Befall einer Bakterienzelle ihr Erbgut in das des Wirtes einzubauen und mit diesem durch Zellteilung auf die Tochterzellen vererbt zu werden (lysogener Lebenszyklus). In diesem Stadium wird der eingebaute Phage als Prophage bezeichnet. Sollte der Prophage Virulenz- oder Resistenzgene enthalten, kann das befallene Bakterium die neuen Eigenschaften ausbilden, so dass es Toxine bildet oder resistent gegen Antibiotika wird. Unter Stressbedingungen wie UV-Licht kann der temperente Phage wieder in den virulenten Zyklus übergehen. Diese Eigenschaft muss für therapeutisch eingesetzte Phagen getestet sein und wäre ein K.O.-Kriterium (siehe auch „Wie sind Bakteriophagen gesetzlich eingeordnet? oder Welche Bedingungen müssen Phagen erfüllen,…?“)(www.bfr/bund.de)
Phagen, die zur therapeutischen Behandlung von Menschen oder Tieren oder zur Bekämpfung bakterieller Krankheitserreger innerhalb der Lebensmittelproduktion eingesetzt werden sollen, müssen eingehend biologisch und bezüglich ihres Erbguts charakterisiert sein. Es kommen für solche Anwendungen ausschließlich virulente Phagen in Frage, die mittels nicht krankmachender Bakterien vermehrt werden können. Die Phagen sollten fähig sein, sich in den befallenen Bakterien intensiv zu vermehren und viele neugebildete Phagen freizusetzen. Des Weiteren sollten sie ein breites Spektrum innerhalb der zu bekämpfenden Bakterien-Spezies aufweisen. Darüber hinaus sollten die Phagen eine hohe Stabilität gegenüber Umwelteinflüssen aufweisen und eine möglichst geringe Resistenzentwicklung in den Zielbakterien hervorrufen. Ihr Erbgut muss frei von Merkmalen sein, die eine Veränderung zu einem krankmachenden oder resistenzbildenden Bakterium begünstigen. Die Fähigkeit, Teile des Phagen-Erbguts in Bakterien zu übertragen, sollte nur gering ausgeprägt sein. Schließlich sollten die Phagen keine Allergien fördern und toxikologisch unbedenklich sein. (www.brf/bund.de)
Ja, Phagen können auch antibiotikaresistente Bakterien zerstören.
Die am häufigsten vorkommenden Phagen zeigen eine recht hohe Stabilität gegenüber Umwelteinflüssen. So können sie auch über längere Zeiträume von einigen Wochen bis hin zu Jahren stabil sein, sowohl bei Trockenheit, höheren Temperaturen bis etwa 60 ºCelsius, pH-Werten zwischen etwa 5 und 9 und gegenüber Salzen. Durch UV-Licht können Phagen jedoch geschädigt werden. Außerdem ist zu beachten, dass es bezüglich der Stabilität große Unterschiede zwischen Phagen geben kann und dass die Stabilität und Aktivität von verschiedenen Faktoren abhängig ist. So lagern sich Phagen, die z. B. auf Lebensmittel gesprüht werden, meist an diese an, so dass sie nicht mehr beweglich und damit in ihrer Aktivität eingeschränkt sind. (www.bfr/bund.de)
Ja, es gibt verschiedene Möglichkeiten einer Resistenzbildung von Bakterien gegenüber Phagen. Am häufigsten ist eine Resistenz durch Veränderung des Erbguts dahingehend, dass die bakteriellen Rezeptoren so verändert werden, dass die Phagen nicht mehr binden können. Allerdings wird dadurch oft auch die Fitness oder das krankmachende Potential der Bakterien verringert. Darüber hinaus können die Aufnahme und Vervielfältigung des Phagen-Erbguts verhindert und bakterielle Resistenzen durch sogenannte Restriktionsenzyme und CRISPR/Cas-Systeme hervorgerufen werden, die das in die Zelle eingedrungene Phagen-Erbgut zerschneiden und damit unwirksam machen. Es handelt sich dabei um natürliche bakterielle Abwehrmechanismen gegenüber Phagen. Dieser Mechanismus hat seinen Ursprung in Bakterien, wo er zur Abwehr fremder DNA, etwa von Phagen, dient, auch wenn er inzwischen vielen eher durch die Herstellung gentechnischer Organismen bekannt ist.
Grundsätzlich ist aber festzustellen, dass es eine quasi gemeinsame Weiterentwicklung von Bakterien und Phagen gibt. Das bedeutet, dass bei einer Resistenzbildung der Bakterien die Phagen recht leicht durch Verändern ihres Erbmaterials dieser Resistenz entgegenwirken. (www.bfr/bund.de)
Bakteriophagen sind in flüssiger Form und werden in einer Nährlösung gelagert. Sie sind je nach Bahandlungsaufwand in 10ml, 100ml oder 500 ml Flaschen abgefüllt.
